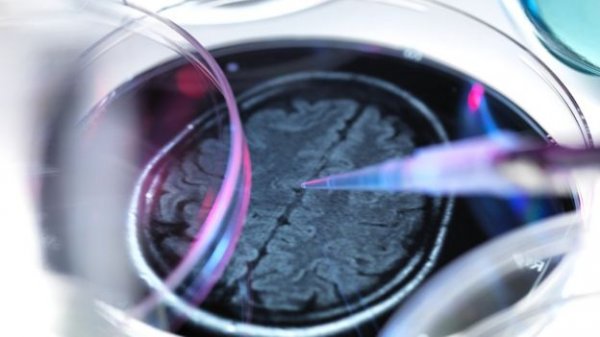

2024年8月,全球长寿纪录的榜单上,一个传奇的名字划下了句点。Maria Branyas
Morera,这位
🔖
大脑,
癌症,
变异,
遗传,
细菌,
细胞,
传说,
科学家,
环境,
基因,
微生物,
睡眠,
长寿,
病毒,
瘤,
癌细胞,
肿瘤,
阿兹海默症,
食物,
疾病,
塑胶,
修复,
细胞分裂,
分裂,

我们从小就被教导,生老病死是自然界的铁律。你有没有想过,如果有一天,“变老”不再是生命的必然,而是一种可以被“治疗”
🔖
大脑,
感染,
算法,
僵尸,
细胞,
科学家,
人工智能,
基因,
降血压,
长寿,
猴子,
阿兹海默症,
糖尿病,
器官移植,
疾病,
抗衰老,
修复,
细胞分裂,
分裂,

研究发现人类老化过程在44岁和60岁会突然加速。(Shutterstock)
🔖
遗传,
细菌,
科学家,
基因,
微生物,
病毒,
阿兹海默症,
骨骼,
疾病,
基因组,
酒精,

忧郁症或阿兹海默症?前额叶皮质的双面效应
额叶损伤病患遇到的记忆问题,跟我们在日常生活中所面对的记忆
🔖
大脑,
感染,
记忆力,
科学家,
记忆,
睡眠,
阿兹海默症,
糖尿病,
疾病,
跑步,
脑退化,
酒精,

男性细胞中的X(左)和Y染色体。(Jonathan Bailey, National Human G

新研究发现了一个与阿兹海默症相关的基因。(Shutterstock)
科学家发现阿茨海默

阿兹海默症患者的大脑(右侧)与正常大脑(左侧)的对比图。(Shutterstock)
以

人脑内有一个超级计算中心。(Shutterstock)
人们惊叹于美国宇航局(NASA)
🔖
大脑,
细胞,
科学家,
探测器,
火箭,
睡眠,
阿兹海默症,
食物,
疾病,
脑细胞,
质量,

老年失智症是当今社会让许多人谈虎色变的疾病。人们愿意在年轻的时候尽一切努力避免自己患上失智症。新研究发现,侧卧睡觉
🔖
大脑,
记忆力,
细胞,
科学家,
记忆,
睡眠,
失眠,
阿兹海默症,
疾病,
神经系统,
脑细胞,
神经元,
老年失智症,

老年失智症是当今社会让许多人谈虎色变的疾病。人们愿意在年轻的时候尽一切努力避免自己患上这种疾病。新研究发现,侧卧睡
🔖
大脑,
记忆力,
细胞,
科学家,
记忆,
太阳,
睡眠,
失眠,
阿兹海默症,
疾病,
神经系统,
脑细胞,
神经元,
老年失智症,

加州大学一项新研究发现,脑细胞清理有缺陷的蛋白质分子的能力逐渐下降,才是导致阿兹海默症(Alzheimer’s)的
🔖
大脑,
细胞,
科学家,
生物学,
阿兹海默症,
食物,
疾病,
氨基酸,
脑细胞,
神经元,
老年失智症,

科学家根据追踪多个社区群组几十年累积的数据,开发出一套能够评估每个人大脑认知力年龄的方法。研究者称,这个评估结果可

微生物培养是制药的起步环节。在地面环境制药业已有了成熟的设备,但显然只适合于地面的重力环境。科学家现在开始设计适合
🔖
细菌,
科学家,
环境,
国际空间站,
微生物,
阿兹海默症,
糖尿病,
疾病,
重力,
空间站,

一份刚发表在《科学》(Science)期刊上的研究发现,熟睡期的脑电波刺激大脑分泌脑脊液,负责清除大脑中的毒素蛋白
🔖
大脑,
记忆力,
科学家,
记忆,
睡眠,
阿兹海默症,
做梦,
疾病,
修复,
核磁共振,

近期发表在《自然-通信》(Nature
Communications)期刊上的报告称,研究者发明了一种扫描眼睛即可

阿兹海默症(Alzheimer’s,也称老年失智症)影响大脑记忆功能和思考能力。但是这种疾病不容易确诊,与淀粉样蛋白、
🔖
大脑,
fda,
细胞,
科学家,
记忆,
阿兹海默症,
疾病,
脑细胞,
神经元,
老年失智症,

最近刊登在《细胞》杂志上的一篇论文,列出了目前科学家已知的九大老化机理。研究者们认为,如果能找到所有
🔖
大脑,
变异,
dna,
僵尸,
老鼠,
遗传,
细胞,
科学家,
基因,
记忆,
阿兹海默症,
食物,
糖尿病,
疾病,
抗衰老,
修复,
分裂,
干细胞,
染色体,

根据美国农业部的数据,2016年美国人共消耗了近1100万吨糖,其中大部分是运动饮料和苏打水等含糖饮

记忆可以移植吗?你想知道别人的记忆吗?某一天你的亲人从你生命中消失,你想不想知道他的记忆呢?将来我们或许真的可以复制

以往在20世纪的医学观念上,认为神经元在出生后就不会更新、大脑细胞也是逐渐减少。不过现在有越来越多研究显示,这一理
🔖
大脑,
记忆力,
细胞,
记忆,
阿兹海默症,
疾病,
脑细胞,
神经元,
分裂,
干细胞,

来自世界著名医疗机构“克利夫兰诊所”的科学家们近日在《实验医学杂志》上发表文章,称他们通过抑制小鼠大

1. 长期睡眠不足记忆会恶化。
加州柏克莱大学的科学家们已经证实,睡眠不足会让记忆力恶化并引起阿兹海默
🔖
大脑,
鱼油,
记忆力,
细胞,
科学家,
记忆,
睡眠,
阿兹海默症,
食物,
脑细胞,
质量,

相信有蛀牙的朋友一定还记得修补时的滋味,真的是害怕看牙医,不过近期医学界发现一项叫做Tideglus

吃糖?不好。给糖?不要。自从临床上与研究界得到一致共识,吃太多的糖,除了让腰围大,更是导致代谢型疾病的高危险因子之
🔖
癌症,
感染,
抗生素,
老鼠,
遗传,
细菌,
细胞,
科学家,
环境,
基因,
记忆,
阿兹海默症,
糖尿病,
疾病,
细胞分裂,
分裂,

科学家说,火星将会被经过基因工程改造、像星际争霸战(Star Trek)里的超人类所统治。
🔖
癌症,
感染,
宇宙,
细胞,
科学家,
环境,
地球,
基因,
大象,
辐射,
中风,
阿兹海默症,
疾病,
免疫力,
基因改造,
太空人,
重力,
干细胞,

脑细胞在2个月大的胎儿身上形成相似的大脑回路,如今它们让科学家有机会检视大脑和所有疾病发展的方式。

算了吧
你以为你透过换成喝减肥碳酸饮料来过着很精采的生活和减少糖摄取量至零?如果有这么简

■有什么方法可以让失智症(dementia)晚点找上门来呢?除了经常动脑、运动、维持社交生活…..等等方法以外,长期

并不是以塑土和黏固粉来填充我们已被蛀蚀的牙齿,而是使用一种全新的方法,让干细胞(stem cells

澳洲布里斯本的科学家发明了一种非侵入性的超音波技术,在所有阿兹海默症的受试动物中,竟使其中的75%完
🔖
大脑,
感染,
老鼠,
细菌,
细胞,
科学家,
记忆,
阿兹海默症,
疾病,
声波,

一种新的大脑机制隐藏在明显的地方。
研究人员发现一种全新的机制,控制大脑神经细胞相互沟通

随着人们寿命的延长,患老年痴呆的人数也开始增加
据科学研究显示,讲话没有条理,漫无边际可

这个大脑博物馆位于秘鲁一个叫Santo Toribio de
Mogrovejo的医院内,这家拥

看牙医很痛苦,牙医拿电钻钻你的牙齿,那声音让人心生恐惧!但医学界发现了叫做Tideglusib的药物,能会让传统的临

阿兹海默症(Alzheimer’s
disease)可能是老人失智症(dementia)最主要的罪魁祸首了。去

# noahlin 投递译稿:
游戏玩家们通过玩一款以科学基础的网络游戏Foldit,在得到同等的生物化学数

阿兹海默症疾病对于患者和他们所爱的人,可以说是破坏性极大。
神经科学界被一项临床试验成功

撇开“心理变态是否确实是一种心理障碍,如果是,那它的定义又是什么”这个议题不论,医学界针对心理变态已经有一些被广泛接受

铝锅真能引起老年痴呆症?误会大了!
网络流传认为铝锅会导致老年痴呆症。铝制压力锅,尤其是铝合金

PingWest / 光谱
2014 年,理论物理学家史蒂芬·霍金给脱口秀主播约翰·奥利佛讲了一个故事:科学家
🔖
化疗,
癌症,
感染,
自闭症,
细胞,
物理学,
寄生虫,
科学家,
人工智能,
中风,
疟疾,
癌细胞,
阿兹海默症,
疾病,
孵化,

美国神经学家詹姆斯佛伦(James H. Fallon)发现,自己的脑部结构与变态杀人犯如出一辙。

下面是由Mark Mattson,现任美国国家老龄化研究所(National Institute on Ag
🔖
大脑,
化疗,
癌症,
dna,
老鼠,
进化,
细胞,
苍蝇,
记忆,
白鼠,
长寿,
阿兹海默症,
食物,
糖尿病,
疾病,
白血球,
神经系统,
神经元,
修复,
干细胞,

斯坦福大学的研究人员结论出,以多重步骤的方式,透过基因巧妙处理和眼睛底部运动,能够重新建立一个最小量的细

“早睡早起身体好”似乎已经是老生常谈,但是!睡眠不足引发的现象可能比你想得还~要~多~,甚至连你笨都是因
🔖
癌症,
感染,
疫苗,
记忆力,
科学家,
基因,
记忆,
睡眠,
阿兹海默症,
食物,
糖尿病,
疾病,
免疫力,

两个观念,一个解决方法
我们都知道粒线体(mitochondria)是细胞的发电机,它引起产生
🔖
老鼠,
细胞,
科学家,
基因,
生物学,
中风,
阿兹海默症,
疾病,
神经元,
修复,

讲德语的人,会多考虑他们的目标。
通两种语言的人拿到所有好处;好的就业前景、认知激励、甚至是保

鲨鱼在海洋食物链中处于最高的位置,也是守护海洋生态的重要角色,一直以来却遭到过量捕捞,都是因为鱼翅而
🔖
fda,
海洋生物,
环境,
鲨鱼,
虐待动物,
汞,
阿兹海默症,
鱼翅,
食物,
水母,
鲨,
污染,
神经系统,
海水,

对于许多人来说,父母的衰老疾病是一个无法回避的大问题。身体上的病痛或许还比较容易判断,然而神经或者说大脑认知层面上
来自英国的研究人员发现,阿兹海默症在某些医疗过程中可能会像克雅氏病(人类海绵状脑病)一样传播。被污染

